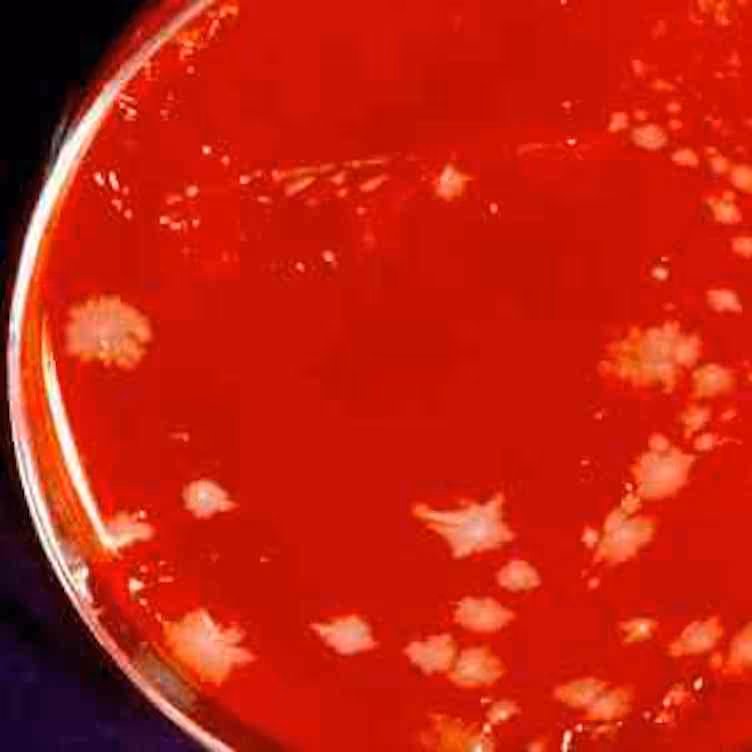

Compliance & CE Courses
Subscriptions to Compliance & CE include access to all 200+ courses listed below. Deliver OSHA safety training courses to your employees, provide CE for ASCP, AMT, and state license maintenance, build custom online courses and checklists, and track & document all training activities with one easy-to-use online system.